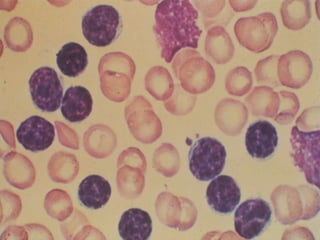
Microvessel Density in DLBCLCardesa-Salzmann et al, Haematol 2011 (e-pub ahead of print)

This document discusses challenges in the design and interpretation of early phase clinical trials in hematology-oncology. It notes problems such as slow accrual, lack of good preclinical models and surrogate endpoints, and high false positive rates when relying on a single study with short follow-up. The document advocates considering alternative trial designs like adaptive randomization and enrichment to accelerate drug development while minimizing false results. It also stresses recognizing tumor heterogeneity and understanding biology to reduce false negatives and properly evaluate new agents.